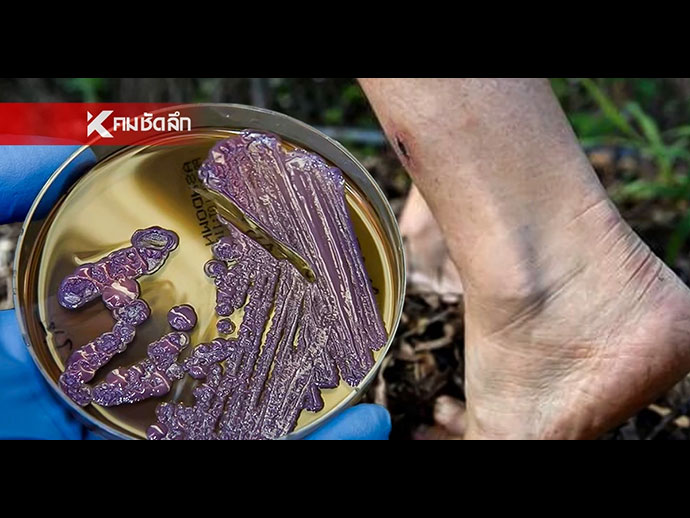

โรคไข้ดิน คืออะไร เปิดอาการ-วิธีป้องกัน “โรคเมลิออยด์” อันตรายถึงตายหากรักษาช้า
ทำความรู้จัก “โรคไข้ดิน” หรือ โรคเมลิออยด์ (Melioidosis) ภัยร้ายที่มากับดินและน้ำ จากการประกาศเตือนของรัฐบาลที่พบการแพร่ระบาดในไทย มีผู้ป่วยสะสม 732 ราย เสียชีวิต 23 ราย เช็กอาการกลุ่มเสี่ยง วิธีป้องกัน และแนวทางการรักษาจากกรมควบคุมโรค
รัฐบาลโดยกระทรวงสาธารณสุข ติดตามสถานการณ์โรคไข้ดินหรือโรคเมลิออยด์โดสิส (Melioidosis) อย่างใกล้ชิด หลังพบแนวโน้มการระบาดยังคงน่ากังวล โดยข้อมูลตั้งแต่วันที่ 1 มกราคม – 16 เมษายน 2569 พบผู้ป่วยสะสมทั่วประเทศ 732 ราย และมีผู้เสียชีวิต 23 ราย ประกอบกับการเสียชีวิตของ “นินจา” วสันต์พรรษ เพ็งสมยา ช่างภาพสายประกวดนางงามระดับประเทศและนานาชาติด้วยโรคดังกล่าว สร้างความตื่นตัวให้สังคมไทยอย่างมาก เราจะพาทุกคนไปทำความเข้าใจว่าโรคนี้เกิดจากอะไร อาการรุนแรงแค่ไหน และเราจะป้องกันตัวเองอย่างไรไม่ให้ตกเป็นเหยื่อรายต่อไป
โรคไข้ดิน (Melioidosis) คืออะไร?
โรคเมลิออยด์ (Melioidosis) หรือที่คนไทยคุ้นหูในชื่อ “โรคไข้ดิน” คือโรคติดเชื้อที่เกิดจากเชื้อแบคทีเรีย Burkholderia pseudomallei ซึ่งพบได้ทั่วไปในดินและน้ำ โดยเฉพาะในพื้นที่เกษตรกรรม เชื้อชนิดนี้มีความทนทานสูงต่อสภาพแวดล้อม และเป็นโรคระบาดที่พบได้บ่อยในภูมิภาคเอเชียตะวันออกเฉียงใต้และออสเตรเลียตอนเหนือ
ช่องทางการติดต่อ ติดเชื้อได้อย่างไร?
ข้อมูลจากกรมควบคุมโรค ระบุว่ามนุษย์สามารถรับเชื้อเข้าสู่ร่างกายได้ 3 ทางหลัก ได้แก่
การสัมผัสทางผิวหนัง: เชื้อเข้าทางบาดแผล หรือผิวหนังที่เปื่อยจากการแช่น้ำ/สัมผัสดินเป็นเวลานาน
การดื่มกิน: ดื่มน้ำหรือกินอาหารที่ปนเปื้อนเชื้อเข้าไป
การสูดดม: หายใจเอาฝุ่นละอองดินที่มีเชื้อปนเปื้อนเข้าไป โดยเฉพาะในช่วงหลังฝนตกใหม่ๆ
อาการของโรคไข้ดิน สังเกตสัญญาณเตือน
โรคไข้ดินได้ชื่อว่าเป็น “นักพรางตัว” เนื่องจากมีอาการคล้ายกับหลายโรค เช่น วัณโรค หรือปอดบวม โดยอาการมีตั้งแต่เฉียบพลันไปจนถึงเรื้อรัง ดังนี้
ภาพจาก iStock
ติดเชื้อที่ปอด: มีไข้ ไอ มีเสมหะ เจ็บหน้าอก (คล้ายปอดอักเสบ)
ติดเชื้อในกระแสเลือด: ไข้สูง ช็อก ความดันตก (มีความเสี่ยงเสียชีวิตสูงมาก)
ติดเชื้อเฉพาะที่: เกิดฝี หนอง ตามผิวหนัง ต่อมน้ำเหลืองโต หรือฝีในตับ/ม้าม
ใครคือกลุ่มเสี่ยงโรคไข้ดิน
แม้คนสุขภาพแข็งแรงจะติดเชื้อได้ แต่กลุ่มที่มีความเสี่ยงอาการรุนแรงคือ
ผู้ป่วยโรคเบาหวาน (กลุ่มเสี่ยงอันดับ 1)
ผู้ป่วยโรคไตเรื้อรัง
ผู้ที่มีภูมิต้านทานต่ำ หรือดื่มสุราเรื้อรัง
ผู้ที่ทำงานคลุกคลีกับดินและน้ำโดยไม่สวมอุปกรณ์ป้องกัน
การรักษาและวิธีป้องกัน
รักษาได้ไหม? โรคไข้ดินสามารถรักษาได้ด้วยยาปฏิชีวนะ แต่ต้องใช้เวลานาน (ประมาณ 3-6 เดือน) และต้องได้รับการวินิจฉัยที่รวดเร็ว หากติดเชื้อในกระแสเลือดและรักษาช้า อัตราการเสียชีวิตจะสูงถึง 40-50%
วิธีป้องกันตนเอง
หลีกเลี่ยงการลุยน้ำ ลุยโคลน ด้วยเท้าเปล่า หากจำเป็นควรสวมรองเท้าบูท
หากมีบาดแผล ให้รีบทำความสะอาดและหลีกเลี่ยงการสัมผัสดิน/น้ำจนกว่าแผลจะแห้ง
ดื่มน้ำที่สะอาด หรือน้ำต้มสุกเท่านั้น
หากมีไข้สูงติดต่อกันเกิน 2-3 วัน โดยเฉพาะหลังไปสัมผัสดินหรือน้ำ ให้รีบพบแพทย์และแจ้งประวัติการสัมผัสดินทันที
โรคไข้ดินไม่ใช่เรื่องใหม่ แต่เป็นภัยที่ใกล้ตัวกว่าที่คิด โดยรัฐบาลได้ประกาศเตือนประชาชนระวังโรคดังกล่าว ย้ำกลุ่มเสี่ยงเกษตรกร-ผู้ป่วยโรคเรื้อรัง เลี่ยงสัมผัสดิน–น้ำ รีบพบแพทย์หากมีอาการ
อากาศร้อนปวดหัว เกิดจากอะไร เช็กสาเหตุใกล้ตัว พร้อมวิธีป้องกันก่อนเสี่ยงฮีทสโตรก
สงสัยไหม? ทำไมอากาศร้อนแล้วต้องปวดหัว พบกับสาเหตุทางการแพทย์ที่ทำให้หลอดเลือดขยายตัว อาการขาดน้ำ และวิธีดูแลตัวเองเบื้องต้นเพื่อป้องกันอาการป่วยรุนแรงในช่วงฤดูร้อน
อากาศเมืองไทยที่ร้อนระอุไม่เพียงแต่ทำให้หงุดหงิดง่าย แต่ยังมาพร้อมอาการ "ปวดหัว" ที่หลายคนหลีกเลี่ยงไม่ได้ ไม่ว่าจะเป็นอาการปวดตุ้บๆ หรือมึนหัวอย่างรุนแรง ไทยรัฐออนไลน์จะพาไปเจาะลึกว่า อาการปวดหัวจากความร้อนเกิดจากสาเหตุใดกันแน่ และเมื่อไหร่ที่อาการเหล่านี้กลายเป็นสัญญาณเตือนภัยที่อันตรายถึงชีวิต
อากาศร้อนปวดหัว เกิดจากอะไร? เปิดสาเหตุทางการแพทย์ที่หลายคนไม่รู้
เมื่ออุณหภูมิภายนอกสูงขึ้น ร่างกายมนุษย์จะมีกลไกการตอบสนองเพื่อรักษาอุณหภูมิในร่างกายให้คงที่ ซึ่งกระบวนการเหล่านี้เองที่เป็นต้นเหตุของอาการปวดหัว โดยแบ่งออกเป็นสาเหตุหลักได้ดังนี้
1. หลอดเลือดขยายตัว
เมื่อร่างกายร้อนจัด หลอดเลือดบริเวณผิวหนังและสมองจะขยายตัวขึ้นเพื่อช่วยระบายความร้อน การขยายตัวอย่างรวดเร็วนี้ส่งผลกระทบต่อเส้นประสาทรอบหลอดเลือด ทำให้เกิดอาการปวดหัวแบบตุ้บๆ คล้ายกับอาการไมเกรน
2. ภาวะขาดน้ำ
อากาศร้อนทำให้เสียเหงื่อมาก หากดื่มน้ำไม่เพียงพอ ปริมาณเลือดในร่างกายจะลดลงและมีความเข้มข้นมากขึ้น ส่งผลให้สมองได้รับออกซิเจนไม่เพียงพอ จนเกิดอาการมึนงงและปวดศีรษะตามมา
3. แสงแดดจ้าและการเกร็งตัวของกล้ามเนื้อ ments
แสงแดดที่สว่างเกินไปเป็นตัวกระตุ้น ชั้นดีสำหรับผู้ป่วยไมเกรน นอกจากนี้ การหรี่ตาหรือเกร็งกล้ามเนื้อใบหน้าและบ่าไหล่ท่ามกลางแดดจัดติดต่อกันเป็นเวลานาน ยังทำให้เกิดอาการปวดหัวจากความเครียดได้เช่นกัน
วิธีแก้ปวดหัวจากอากาศร้อนเบื้องต้น ดูแลตัวเองอย่างไรให้ฟื้นตัวเร็ว
หากเริ่มมีอาการปวดหัวเมื่อต้องเผชิญกับอากาศร้อนจัด แนะนำให้ปฏิบัติตามขั้นตอนดังนี้
รีบเข้าที่ร่ม: ย้ายตัวเองไปอยู่ในพื้นที่ที่มีอากาศถ่ายเทสะดวก หรือห้องที่มีเครื่องปรับอากาศ
จิบน้ำสะอาด: ค่อยๆ จิบน้ำเปล่าอุณหภูมิห้อง ไม่ควรดื่มน้ำเย็นจัดทันทีเพื่อป้องกันอาการ Cold Shock
เช็ดตัวระบายความร้อน: ใช้ผ้าชุบน้ำเช็ดบริเวณซอกคอ ข้อพับ และใบหน้า
พักสายตา: หลีกเลี่ยงการใช้หน้าจอโทรศัพท์มือถือ หรือการจ้องแสงจ้าชั่วคราว
สัญญาณอันตราย! ปวดหัวแบบไหนที่ต้องไปพบแพทย์ด่วน
อาการปวดหัวจากความร้อนอาจเป็นสัญญาณแรกเริ่มของ "โรคลมแดด" หรือ Heatstroke หากมีอาการเหล่านี้ร่วมด้วย ควรรีบนำส่งโรงพยาบาลทันที:
ตัวร้อนจัดแต่ไม่มีเหงื่อออก
มีอาการคลื่นไส้ อาเจียนรุนแรง
สับสน มึนงง พูดจาไม่รู้เรื่อง
มีอาการชักหรือหมดสติ
อาการปวดหัวจากอากาศร้อนเป็นเรื่องที่ป้องกันได้ด้วยการปรับพฤติกรรม โดยเฉพาะการดื่มน้ำและการหลีกเลี่ยงแสงแดดจัดในช่วงกลางวัน อย่างไรก็ตาม การหมั่นสังเกตสัญญาณเตือนที่รุนแรงคือสิ่งสำคัญที่จะช่วยลดความเสี่ยงจากการเจ็บป่วยรุนแรงในฤดูร้อนนี้ได้
แจก 4 วิธีเช็ดกระจกให้ใสปิ๊ง ไร้คราบกวนใจ ด้วยเทคนิคที่ทำเองง่ายๆ
การทำความสะอาดกระจกมักเป็นงานบ้านที่สร้างความหงุดหงิดใจให้หลายคน เพราะบางครั้งเช็ดเสร็จแล้วมักทิ้งคราบน้ำหรือรอยขุยผ้าเอาไว้ บทความนี้จึงรวบรวม "วิธีเช็ดกระจกให้ใส" และเทคนิคการ "เช็ดกระจกไม่ให้เป็นคราบ" ด้วยอุปกรณ์ที่หาได้ง่ายในบ้าน เพื่อให้กระจกกลับมาสะอาด เงางาม และดูเหมือนใหม่อีกครั้ง
ทำไมหลังเช็ดกระจก ถึงเป็นคราบ?
ก่อนที่จะไปดูวิธีทำความสะอาด มาทำความเข้าใจก่อนว่าสาเหตุที่ทำให้กระจกเกิดคราบหลังการเช็ด มักเกิดจาก 3 ปัจจัยหลัก เหล่านี้
การเช็ดกระจกในขณะที่มีแดดจัด ความร้อนจากแสงแดดจะทำให้น้ำยาหรือน้ำระเหยเร็วเกินไป จนทิ้งคราบน้ำเอาไว้บนกระจก
การเลือกใช้ผ้าที่ไม่เหมาะสม การใช้ผ้าที่มีขนหรือผ้าขี้ริ้วทั่วไป จะทำให้ทิ้งรอยขุยผ้าและคราบฝุ่นบนกระจก
การฉีดน้ำยามากเกินไป น้ำยาที่ตกค้างอยู่บนกระจก เมื่อแห้งแล้วจะกลายเป็นคราบขาวฝังแน่น
อุปกรณ์ที่ควรเตรียมก่อนทำความสะอาด
เพื่อให้การเช็ดกระจกได้ผลลัพธ์ที่ดีที่สุด ควรเตรียมอุปกรณ์ดังต่อไปนี้
ผ้าไมโครไฟเบอร์ เป็นผ้าที่ซึมซับน้ำได้ดีและไม่ทิ้งขุยผ้า เหมาะสำหรับการเช็ดกระจกที่สุด หาซื้อได้ง่าย
ที่รีดน้ำกระจก ช่วยปาดน้ำและคราบสกปรกออกได้อย่างหมดจดและรวดเร็ว
กระบอกฉีดน้ำ ใช้สำหรับใส่น้ำยาทำความสะอาด เพื่อให้พ่นกระจายตัวได้ดี
เคล็ดลับ 4 วิธีเช็ดกระจกให้ใสปิ๊ง ไร้คราบกวนใจ
1. สูตรน้ำส้มสายชูผสมน้ำเปล่า
น้ำส้มสายชูมีฤทธิ์เป็นกรดอ่อนๆ ช่วยขจัดคราบฝังแน่นและคราบหินปูนได้ดี
วิธีทำ ผสมน้ำส้มสายชูกับน้ำเปล่าในอัตราส่วน 1:1 ใส่กระบอกฉีดน้ำ แล้วนำไปฉีดบนกระจก จากนั้นใช้ผ้าไมโครไฟเบอร์เช็ดถูเบาๆ หรือใช้ที่รีดน้ำปาดจากบนลงล่าง
2. สูตรน้ำยาล้างจาน
เหมาะสำหรับกระจกที่มีคราบมันเกาะติด เช่น กระจกในห้องครัว หรือกระจกโต๊ะอาหาร
วิธีทำ หยดน้ำยาล้างจาน 2-3 หยดลงในน้ำเปล่า 1 กะละมังเล็ก ใช้ฟองน้ำชุบและเช็ดทำความสะอาดกระจก จากนั้นใช้ที่รีดน้ำปาดฟองออก แล้วเช็ดเก็บรายละเอียดด้วยผ้าไมโครไฟเบอร์แห้ง
3. เช็ดกระจกด้วยกระดาษหนังสือพิมพ์
เป็นวิธีสุดคลาสสิกที่ยังคงใช้ได้ผลดี เนื่องจากหมึกพิมพ์ในกระดาษหนังสือพิมพ์มีส่วนช่วยในการขัดเงากระจก
วิธีทำ ขยำกระดาษหนังสือพิมพ์ให้เป็นก้อน พรมน้ำเปล่าหรือน้ำยาเช็ดกระจกเล็กน้อย แล้วนำไปเช็ดวนเป็นวงกลมบนกระจก จะช่วยให้กระจกใสและไม่ทิ้งขุยผ้า
4. สูตรน้ำยาล้างคอนแทคเลนส์ (สำหรับกระจกเงาหรือแว่นตา)
หากต้องการเช็ดกระจกเงาในห้องน้ำ หรือกระจกบานเล็กให้ใสปิ๊ง น้ำยาล้างคอนแทคเลนส์เป็นอีกหนึ่งตัวช่วยที่น่าสนใจ
วิธีทำ หยดน้ำยาล้างคอนแทคเลนส์ลงบนผ้าไมโครไฟเบอร์ แล้วนำไปเช็ดกระจก จะช่วยลดคราบฝุ่นและรอยนิ้วมือได้อย่างมีประสิทธิภาพ
เทคนิคง่ายๆ ทำให้กระจกให้ใสปิ๊ง
ข้อควรระวังในการเช็ดกระจก
ควรเช็ดจากบนลงล่าง เพื่อให้น้ำและสิ่งสกปรกไหลลงสู่ด้านล่าง ช่วยลดการเกิดคราบซ้ำซ้อน
ทำความสะอาดกรอบหน้าต่างก่อน ควรปัดฝุ่นที่กรอบและรางหน้าต่างก่อนเสมอ เพื่อป้องกันฝุ่นปลิวมาเกาะกระจกที่เพิ่งทำความสะอาดเสร็จ
หลีกเลี่ยงการใช้น้ำยาที่มีฤทธิ์กัดกร่อนสูง เพราะอาจทำลายพื้นผิวหรือสารเคลือบของกระจกได้
การ "เช็ดกระจกให้ใส" และ "เช็ดกระจกไม่ให้เป็นคราบ" ไม่ใช่เรื่องยุ่งยากอีกต่อไป เพียงแค่เลือกใช้อุปกรณ์ที่ถูกต้องและใช้วิธีทำความสะอาดอย่างถูกขั้นตอน เช่น การใช้ผ้าไมโครไฟเบอร์ การใช้สูตรน้ำส้มสายชู หรือการเลือกช่วงเวลาที่ไม่มีแดดจัด แค่นี้กระจกบานเก่าในบ้านก็จะกลับมาใสสะอาด ช่วยให้บ้านดูสว่างและน่าอยู่มากยิ่งขึ้น.
เอลนีโญ คืออะไร เปิดสาเหตุปี 2026 โลกร้อนทุบสถิติ จับตา "ไทย" รับมือภัยแล้งระยะยาว
โลกร้อนไม่ได้เป็นแค่เรื่องของอนาคต แต่คือวิกฤตที่กำลังเกิดขึ้นจริงในฤดูร้อนปี 2026 เมื่อปรากฏการณ์ "เอลนีโญ" กลับมาแผลงฤทธิ์อีกครั้งด้วยความรุนแรงระดับ "ซูเปอร์" ส่งผลให้อุณหภูมิทั่วโลกพุ่งสูงทุบสถิติ และประเทศไทยกำลังเผชิญกับบททดสอบครั้งใหญ่ทั้งภัยแล้งและฝุ่นควัน
เอลนีโญ 2026 เมื่อมหาสมุทรแปซิฟิกอุ่นขึ้นจนโลกต้องสั่นสะเทือน
เอลนีโญ (El Niño) คือปรากฏการณ์ทางธรรมชาติที่เกิดจาก "ลมค้า" (Trade Winds) บริเวณมหาสมุทรแปซิฟิกอ่อนกำลังลง ส่งผลให้น้ำทะเลอุ่นไหลย้อนกลับมาทางฝั่งตะวันออก (หน้าฝนของฝั่งอเมริกา) แทนที่จะพัดไปทางฝั่งตะวันตก (เอเชีย) ตามปกติ การเปลี่ยนแปลงนี้ทำให้เกิดการสะสมความร้อนมหาศาลในชั้นบรรยากาศโลก
ทำไมปี 2026 โลกถึงร้อนทุบสถิติ
นักวิทยาศาสตร์ระบุว่าปี 2026 คือการ "รวมตัวกันของวิกฤต" จาก 2 ปัจจัยหลัก ได้แก่ การกลับมาของซูเปอร์เอลนีโญ ที่อุณหภูมิผิวน้ำทะเลสูงกว่าค่าเฉลี่ยถึง 2 องศาเซลเซียส ปลดปล่อยความร้อนสะสมเข้าสู่ชั้นบรรยากาศโลกอย่างรวดเร็ว
ภาวะโลกร้อนสะสม (Global Warming) มาจากก๊าซเรือนกระจกที่มนุษย์สร้างขึ้นทำให้อุณหภูมิพื้นฐานของโลกสูงอยู่แล้ว เมื่อมาเจอกับเอลนีโญ จึงกลายเป็นตัวเร่งให้อุณหภูมิพุ่งทะลุเพดาน
ผลกระทบต่อประเทศไทยที่ต้องจับตา
หลายพื้นที่ของไทยอาจเห็นอุณหภูมิแตะ 45-48 องศาเซลเซียสในช่วงเมษายน ซึ่งทำให้อากาศร้อนจัดอาจทุบสถิติ
ฝนทิ้งช่วงและภัยแล้ง ในช่วงนี้จากปริมาณน้ำในเขื่อนลดต่ำลง กระทบโดยตรงต่อภาคเกษตรกรรม โดยเฉพาะข้าวและอ้อย มาพร้อม ฝุ่น PM 2.5 รุนแรงขึ้น ทำให้สภาพอากาศที่แห้งแล้งทำให้ไฟป่าเกิดง่ายขึ้น และการระบายอากาศที่แย่ลงส่งผลให้ฝุ่นพิษสะสมตัวหนาแน่นกว่าปีก่อนๆ
สิ่งที่น่ากังวล คือ สุขภาพในยุคที่เอลนีโญรุนแรงระดับสูงสุด การดูแลตัวเองไม่ใช่เรื่องเล่นๆ นอกจากต้องสังเกตสัญญาณเตือนจากร่างกาย เช่น ตัวร้อนจัดแต่ไม่มีเหงื่อ มึนไส้ หรือตะคริวแดดแล้ว การพก "ไอเทมดับร้อน" ที่ทันสมัยและช่วยลดอุณหภูมิร่างกายได้ทันทีจึงเป็นเรื่องจำเป็นสำหรับคนเมืองและคนทำงานกลางแจ้ง
เตรียมตัวให้พร้อมก่อนออกจากบ้านด้วยลิสต์อาการเฝ้าระวังและอุปกรณ์ช่วยลดอุณหภูมิที่เหมาะกับยุคโลกร้อนทุบสถิติ อ่านเพิ่มเติมได้ที่ Checklist อาการต้องระวัง และไอเทมดับร้อนที่ต้องพกติดตัวในยุคเอลนีโญครองเมือง
‘วัคซีนงูสวัด’ ไม่ใช่วัคซีนกันโรคทางเพศสัมพันธ์ (ตอนจบ)
โรคงูสวัด คืออะไร? โรคงูสวัดเกิดจากเชื้อเดียวกับอีสุกอีใส หลังจากหายแล้ว เชื้อจะซ่อนอยู่ในร่างกาย และอาจกลับมาเป็นอีกครั้งเมื่อภูมิคุ้มกันลดลง โดยมีลักษณะอาการคือ ตุ่มน้ำใสขึ้นเป็นแนวตามลำตัวหรือใบหน้า มักขึ้นข้างเดียว ปวดแสบปวดร้อนค่อนข้างมาก และโรคงูสวัดไม่ใช่โรคติดต่อทางเพศสัมพันธ์
โรคงูสวัด คืออะไร? โรคงูสวัดเกิดจากเชื้อเดียวกับอีสุกอีใส หลังจากหายแล้ว เชื้อจะซ่อนอยู่ในร่างกาย และอาจกลับมาเป็นอีกครั้งเมื่อภูมิคุ้มกันลดลง โดยมีลักษณะอาการคือ ตุ่มน้ำใสขึ้นเป็นแนวตามลำตัวหรือใบหน้า มักขึ้นข้างเดียว ปวดแสบปวดร้อนค่อนข้างมาก และโรคงูสวัดไม่ใช่โรคติดต่อทางเพศสัมพันธ์ โรคเริม คืออะไร? เริมเกิดจากไวรัสอีกชนิดหนึ่ง มีได้ 2 ตำแหน่งที่พบบ่อย เริมที่ปากตุ่มน้ำใสท่ีริมฝีปาก เริมที่อวัยวะเพศ เป็นโรคติดต่อทางเพศสัมพันธ์ ลักษณะอาการคือตุ่มน้ำใสเป็นกลุ่มแตกเป็นแผลตื้น ๆ แสบเจ็บ และมักกลับมาเป็นซ้ำได้
ทำไมชื่อถึงต่างกัน ทั้งที่ดูคล้ายกัน? ภาษาไทยแยกคำชัดเจน “งูสวัด” ใช้เรียกโรคที่ขึ้นตามลำตัว ส่วน “เริม” ใช้เรียกโรคที่ปากหรืออวัยวะเพศ แม้ทั้งสองโรคจะอยู่ในกลุ่มไวรัสใกล้เคียงกันแต่เป็นคนละชนิดของเชื้อจึงต้องแยกกันทั้งชื่อ อาการ และการป้องกัน
วัคซีนงูสวัด ป้องกันเริมได้หรือไม่? คำตอบคือ ไม่ได้ วัคซีนงูสวัดใช้ป้องกันงูสวัดเท่านั้น ไม่สามารถป้องกันเริมที่ปากหรืออวัยวะเพศได้ แล้วถ้ากังวลเรื่องโรคทางเพศสัมพันธ์ ควรป้องกันอย่างไร? ในความเป็นจริง มีวัคซีนที่เกี่ยวข้องกับโรคทางเพศสัมพันธ์โดยตรง คือ วัคซีนป้องกันเชื้อเอชพีวี (HPV) เชื้อนี้เป็นสาเหตุสำคัญของ มะเร็งปากมดลูก หูดหงอนไก่ และมะเร็งบางชนิด ในอวัยวะเพศ
วัคซีนเอชพีวี จึงเป็นวัคซีนที่ช่วยป้องกันมะเร็งและโรคจากเพศสัมพันธ์ได้จริง สามารถฉีดได้ทั้งผู้หญิงและผู้ชายและยิ่งฉีดก่อนมีเพศสัมพันธ์ ยิ่งได้ประโยชน์สูง แล้วใครควรฉีดวัคซีนงูสวัด? วัคซีนนี้มีประโยชน์มากในกลุ่มผู้ที่มีอายุมาก ผู้ที่มีภูมิคุ้มกันต่ำ ผู้ที่ต้องการลดความรุนแรงของโรค แต่สำหรับคนอายุน้อย สุขภาพแข็งแรง ยังไม่จำเป็นต้องฉีดเป็นประจำ
ประเด็นสำคัญที่อยากฝาก ในปัจจุบันมีการพูดถึงวัคซีนงูสวัดอย่างมาก จนทำให้มีความต้องการฉีดเพิ่มขึ้น และบางช่วงเริ่มเกิดภาวะขาดแคลน การฉีดวัคซีนควรพิจารณาจาก “ความจำเป็น” ไม่ใช่จาก “ความเข้าใจที่คลาดเคลื่อน”
สรุป งูสวัด และ เริม เป็นคนละโรค มีลักษณะคล้ายกันคือเป็นตุ่มน้ำใส เริมที่อวัยวะเพศเป็นโรคติดต่อทางเพศสัมพันธ์ วัคซีนงูสวัด ไม่สามารถป้องกันเริมได้ วัคซีนที่เกี่ยวกับโรคทางเพศสัมพันธ์โดยตรง คือ วัคซีน HPV
ปิดท้าย ในยุคที่ข้อมูลสุขภาพหาได้ง่ายเพียงปลายนิ้ว สิ่งที่ยากกว่าการเข้าถึงข้อมูล คือ การเข้าใจข้อมูลให้ถูกต้อง วัคซีนไม่ใช่สิ่งที่ต้องฉีดให้ครบทุกชนิด แต่คือสิ่งที่ควรเลือก ให้ตรงกับความเสี่ยงของตัวเอง เพราะการป้องกันที่ดีที่สุดไม่ใช่การป้องกันทุกอย่าง แต่คือ การป้องกันให้ถูกเรื่อง…ตั้งแต่แรก.
ศ.เกียรติคุณ น.ท.ดร.นพ.สมพล เพิ่มพงศ์โกศล
รพ.รามาธิบดี คณะแพทยศาสตร์ มหาวิทยาลัยมหิดล...